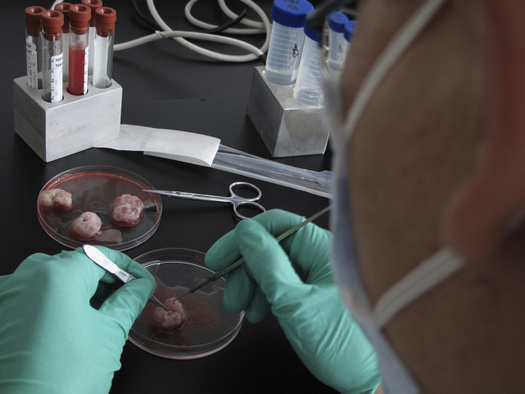

Клонирование человека возможно? Чем копия отличается от оригинала? В чем вообще смысл? Стыдные вопросы про самую обсуждаемую тему в современной биологии
Мы говорим как есть не только про политику. Скачайте приложение.
24 января стало известно, что китайские ученые впервые успешно клонировали приматов способом, который использовался в эксперименте со знаменитой овечкой Долли. Клонирование — одна из самых удивительных и обсуждаемых тем в современной биологии. «Медуза» попросила доктора биологических наук, профессора Сколковского института науки и технологий и Университета Ратгерса Константина Северинова ответить на базовые вопросы о клонировании.
Клонирование — это вообще что?
Клонирование — это процесс или технология получения клонов. Клоном принято называть организм, генетически идентичный или почти идентичный другому. Однояйцевые близнецы — это клоны друг друга, так как оба возникли из одной и той же оплодотворенной яйцеклетки. Растения, возникшие путем вегетативного размножения, — например, размноженные усами кусты клубники, — тоже клоны.
Но ребенок — это не клон своих родителей. У каждого человека в клетках есть двойной набор генов: один набор от отца, другой — от матери. При зачатии и отец, и мать передают своему потомству лишь половину своих генов — по одному набору каждый. При этом какой из дублированных генов отца и матери передается потомству, определяется случаем. Так как версии генов, имеющихся у родителей, немного отличаются друг от друга, то и потомство отличается от родителей. С точки зрения биологии и эволюции это хорошо, потому что увеличивается генетическое разнообразие. Чем разнообразнее популяция, тем больше вероятность, что при изменении условий внешней среды носители каких-то определенных комбинаций генов выживут и оставят потомство.
Однако в условиях, например, товарного сельскохозяйственного производства разнообразие — это источник проблем. Если вы хотите поддерживать стадо ангусов с какими-то определенными свойствами, необходимость получения бычков путем полового размножения неизбежно приводит к тому, что не все потомство будет таким же, как исходные животные, и часть животных придется выбраковывать. Клонирование могло бы решить такую проблему (собственно, в случае с клубникой проблема решена, а вот коровы, увы, усами не размножаются, там все сложнее).
Как ученые вывели овечку Долли? Взяли клетки самки и самца и как-то соединили в пробирке?
Овечку Долли «сделали» следующим образом: взяли клетку вымени овцы и генетический материал этой клетки «подсадили» в яйцеклетку, взятую у другой овцы. При этом собственный генетический материал из этой яйцеклетки был предварительно удален. Заметьте, что после такой подсадки полученная яйцеклетка имела двойной набор генов — такой же, как в клетке вымени. А значит, оплодотворения такой яйцеклетки не требовалось! Эта яйцеклетка была подсажена в матку третьей овцы, которая выносила и родила овечку — Долли.
Овца, родившая Долли, — суррогатная мать: генетически она никак не связана с Долли. Та овца, из яйцеклетки которой развилась Долли, не имеет к ней отношения, так как у нее и у Долли почти нет общих генов. А вот овца, из клетки вымени которой взяли генетический материал для подсадки в яйцеклетку, является «генетической матерью» Долли (а Долли, в свою очередь, ее клоном). Их гены практически идентичны. Отца у Долли не было — с генетической точки зрения им был отец генетической матери Долли, но получается, что одновременно он был ее дедом.

Чем клонированная копия отличается от оригинала? Они как близнецы или не совсем?
Однояйцевые близнецы возникают тогда, когда развивающийся эмбрион разделяется на два (или четыре) эмбриона и каждый из них потом независимо развивается во взрослый организм в утробе матери. В общем, клоны очень похожи на однояйцевых близнецов, только они не рождаются одновременно, а вынашиваются в разное время разными матерями и могут появиться после биологической смерти своего оригинала. Клон создают на основе генетической программы — ДНК, содержащейся в клетке взрослого или умершего организма.
Все клетки нашего тела — потомки оплодотворенной яйцеклетки, которая возникла в момент нашего зачатия. Но это не значит, что клетки нашего тела совершенно идентичны. Всякий раз, когда клетка делится, внутри нее копируются гены, молекулы ДНК. При копировании всегда возникают ошибки, мутации — так же, как случаются опечатки при переписывании длинного текста. При делении клетки организма вроде человека или овцы в ДНК дочерних клеток спонтанно появляется около 50 новых мутаций, не существовавших в ДНК родительской клетки. То есть гены клетки вымени, из которой получили Долли, на самом деле не полностью идентичны генам яйцеклетки, из которой развилась ее мать.
Со времен Долли много было подобных случаев, когда ученые клонировали животных?
После Долли клонировали рыб, лягушек, грызунов (крыс и мышей), собак и кошек, свиней, лошадей и коров. 24 января стало известно о клонировании приматов — длиннохвостых макак. В целом эта процедура применима к любому организму, просто в каждом конкретном случае много времени уходит на подбор оптимальных условий.
Когда научатся клонировать людей? Или уже научились?
Принципиальных проблем в клонировании людей нет. Если поставить такую задачу, нужно будет оптимизировать опыты по подсаживанию генетического материала из клеток взрослого человека в лишенную собственного генетического материала яйцеклетку. Но клонировать людей запрещено из-за этических проблем.
Чем клонирование может помочь человечеству? Запасная печень? Армия клонов? Эксперименты над клонами?
И с армией клонов, и с экспериментами над ними есть неразрешимые этические проблемы, а также некоторые практические сложности — поэтому делать так не будут.
Возьмем двух близнецов. Перед тем как отнять печень одного из них для другого или проделать над одним из них какой-нибудь острый эксперимент, рассуждая, что второй (то есть клон) останется, придется заручиться согласием первого. Он или она могут отказаться, ведь они личности и имеют такие же права, как другие люди. Так вот, если вы создали своих клонов, то они, став людьми, а не куском мяса в пробирке, тоже наверняка будут иметь виды на свою печень, которые будут отличаться от ваших. Так что с печенью или, шире, источником органов проблема в том, что мы не умеем отдельно получать клон печени — в этом случае этических проблем бы не возникало.
По поводу армии клонов. Если вы насоздавали клонов условного депутата Николая Валуева, потому что он большой и устрашающе выглядит, то для получения их в «готовом к употреблению» состоянии вам, а вернее, их суррогатным матерям придется их растить, как растят всех людей, лет до 20. За это время могут поменяться политические режимы — и необходимость пугать сегодняшних врагов отпадет. Кроме того, никак нельзя исключать, что некоторые из клонов решат стать интеллектуалами и не захотят играть в ваши игры, а захотят, например, заниматься молекулярной биологией. И заставить их делать что-то только потому, что они клоны какого-то дяди, который, может, уже давно умер, будет сложно против их воли. Гораздо легче завербовать в свои ряды уже существующих людей.
У клонированных организмов может быть потомство? У них будут какие-то особенности из-за того, что они — потомки клона?
При соблюдении надлежащих условий клонированные организмы не будут отличаться от организмов, возникших естественным путем, и смогут давать потомство. Другой вопрос, что если полностью исключить половое размножение и перейти на клональное, то с течением времени в поколениях клонов неизбежно накопятся мутации, понижающие приспособленность организма. Половое размножение — обмен комбинациями генов для создания новых комбинаций — необходимо для поддержания разнообразия и устойчивости видов в течение более длительного времени в условиях непредсказуемо изменяющейся внешней среды.
Почему многие считают, что клонирование нужно запретить? Что в этом опасного?
Клонирование сельскохозяйственных животных не опасно, а при условии соответствующего развития технологии удобно и выгодно. Проблема возникает, если начать думать про клонирование человека. С животным просто: клонировал, вырастил, съел, например, бифштекс, и можешь быть уверен, что его качество будет одно и то же на протяжении десятилетий. Нас ведь, как правило, не волнует вопрос о том, была ли корова, ставшая источником бифштекса, личностью.
Людей же мы воспринимаем как личностей, индивидуальности. Личность формируется не только генетикой, но и воспитанием, временем и местом, в котором человек родился и сформировался, различными случайными причинами и встречами и другими факторами. Поэтому человеческие клоны не будут одинаковыми личностями (например, однояйцевые близнецы похожи друг на друга внешне, но, безусловно, являются разными людьми со своими собственными жизнями, пристрастиями, разными датами, местами и причинами смерти). Поэтому, пока не существует государственных режимов, в которых можно использовать людей на условные бифштексы, клонирование людей не опасно. Опасно, если появление таких режимов станет возможным.
Константин Северинов
(1) Размножение усами
В садоводстве используется несколько способов размножения клубники. Размножение усами — один из самых распространенных. Нужно дождаться, пока на стеблях появятся отростки (усы), и укоренить их рядом.